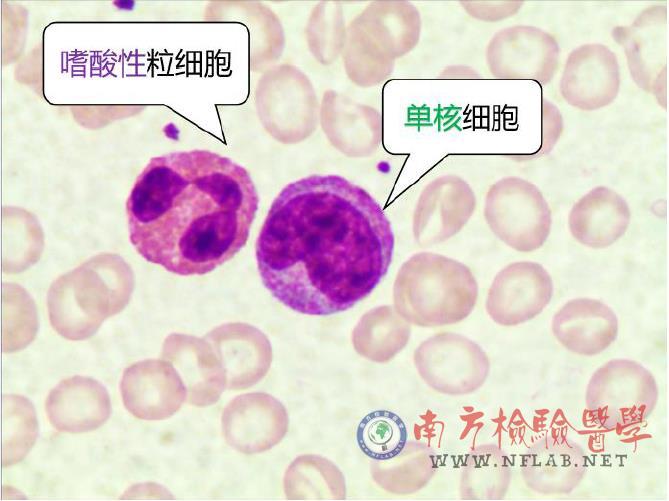

血细胞的自我介绍
嗨!欢迎来到细胞世界!我是血液血细胞,由红细胞、白细胞、血小板组成,是人类血液重要的组成部分。又到年底体检季,相信大家对血常规检查不陌生吧?这份报告上将会出现我的指标分析。那么他们分别代表什么意思呢?我将跟你做一下简单的自我介绍,希望通过我的介绍,你能大致看懂这份报告。
红细胞
我是红细胞,是构成人类血液的主要物质。我没有核心,可我的作用大着呢——我身上的血红蛋白负责运输氧气和二氧化碳,带来能量,使人类能自如呼吸和运动。如果我的伙伴减少了,或者我的身体有缺陷,人们将会产生乏力、心悸、头晕、无神等症状,这就是贫血。这个词你应该不陌生。轻度的贫血(血红蛋白HB90g/L——参考范围下限)问题不大。可是如果贫血时间很长或者很严重,你将无法正常生活!那么当你发现后,是不是应该尽快处理?以下是几种常见的贫血:
当你因为慢性失血丢失了很多构成我所必须的铁,我的体积将会变小,血红蛋白也变少,这时候你应该进行补铁治疗。
当你存在胃炎等消化道疾病,不能很好地吸收维生素B12和叶酸,相反地,我会变大,这时候你就需要补充这两样东西。
如果是因为急性因素导致大出血,应该进行紧急输血。
还有一种贫血叫地中海贫血,是因为我的基因有缺陷,导致蛋白合成不足。这种贫血没有好的治疗方法,只能将问题尽量扼杀在生命孕育之前的阶段。国家免费给新婚夫妻进行地中海贫血基因检查和遗传咨询,避免生出严重的地贫患儿。 不同的贫血有不同的治疗方法,一定要找到原因才好治疗哦!
白细胞
我是白细胞,也叫白血球,是你身体免疫力的卫士。我由中性粒细胞、淋巴细胞、单核细胞、嗜酸性粒细胞以及嗜碱性粒细胞这几个兄弟构成。看看我们是怎么发挥自己力量的吧!
我是中性粒细胞老大,占白细胞多数。我的数量增多时经常见于急性感染、炎症、组织损伤等情况,是身体对外界刺激反应良好的标志。如果数量轻度增多,别慌,那是我的同胞们正在与病菌进行积极的抵抗,很快就能使主人恢复正常。如果是重度增多,居高不下,要警惕大家谈癌色变的“白血病”(血癌)。白血病这个名称的来源就是发现白血球异常。当然白血病不只包括中性粒细胞的异常发育,还有淋巴细胞、单核细胞、红细胞等其他细胞。白血病细胞挤兑正常的细胞,使人体没有正常的抵抗力,容易发生出血、贫血、感染等症状。它的发生与基因突变有关系
我是老二淋巴细胞,是名副其实的免疫细胞。我们的数量决定了你身体免疫力的强弱,尤其在你受到病毒侵犯时我们会挺身而出,并且产生抵抗病毒再次入侵的保护因子——抗体。现在大家注射的灭活新型冠状病毒疫苗也是为了使身体产生抗体,提前防护。知道这点,你应该不会对疫苗产生疑惑了吧?这是我于你身体有益的一面。我还有另一面。当我的数量无法控制地增长,却没有免疫功能,说明我“变坏”了!临床上叫做淋巴细胞增殖性疾病。这个病就厉害了,患者需要去血液科进行规律治疗。
我是老三单核细胞,数量虽然不多,却是白细胞中最大的细胞,可以做变形运动,能吞噬和清除衰老的细胞及其碎片,具有强大的防御功能。
我们老四老五是嗜酸性粒细胞和嗜碱性粒细胞。我们的增多与过敏反应以及寄生虫感染息息相关。

血小板
我是血小板,小小的身体有大大的作用——止血。当我的数量减少,你会面临皮肤出血难止、内脏出血的危险,甚至发生最致命的脑出血。这也是医院检验科会把我们设置成危急值的原因,一般低于30x10^9/L就会有生命危险!当然数量太多也不好。因为异常增多的血小板他们的功能是没有的,会使人们发生出血、血栓、头痛、乏力等情况。

好了,我的介绍就到这儿。希望细胞家族伴您圆满,每个细胞都是快乐的哟!
